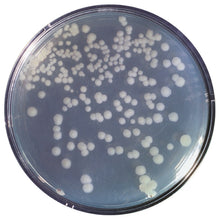
Load image into Gallery viewer, Edvotek 301 Construction and Cloning of a DNA Recombinant

Cloning is frequently performed to study gene structure, function, and to enhance gene expression.
This Edvotek experiment is divided into five modules. Clones are constructed by ligation of a vector and a fragment insert. The constructs are then transformed into competent cells and the cells are grown and selected for resistance. Plasmid DNA is then isolated from the transformants, cleaved with restriction enzymes, and analysed by agarose gel electrophoresis.
Recommended for advanced level courses.
Kit includes: instructions, BactoBeads™, enzymes, plasmid DNA, restriction enzyme dilution buffer, enzyme grade water, standard DNA fragments, restriction enzyme reaction buffer, gel loading solution, agarose powder, electrophoresis buffer, stains, calibrated pipette.
All you need: electrophoresis apparatus and power supply, automatic micropipette with tips, balance, microwave or hot plate, waterbath, large weigh boats for staining, UV transilluminator, floating racks for microtest tubes, pipet pump or bulb, 5 or 10 ml pipets, laboratory glassware, metric rulers, distilled water, ice.
For 5 Plasmid Constructs & Analyses.
Time required: 5 modules in about 5 hours